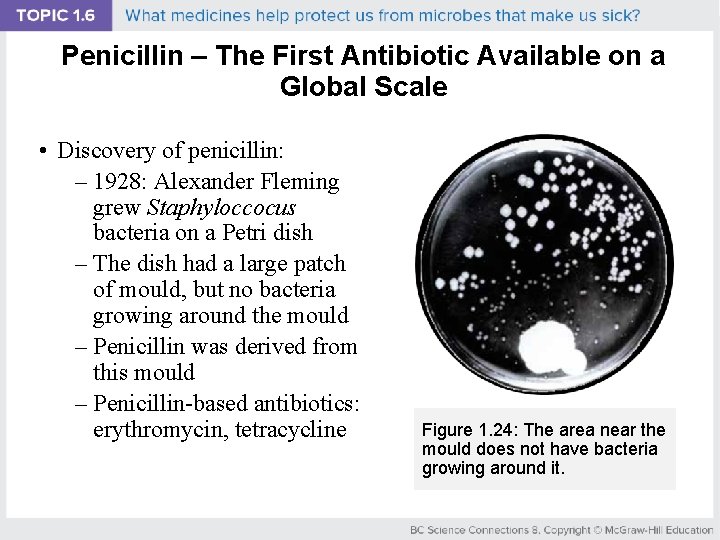
Penicillin – The First Antibiotic Available on a Global Scale • Discovery of penicillin:

BC Science Connections 8 UNIT 1 Life processes

BC Science Connections 8

UNIT 1 Life processes are performed at the cellular level TOPIC 1. 6 What medicines help protect us from microbes that make us sick?

Topic 1. 6: What medicines help protect us from microbes that make us sick? • Kisameet clay from Kisameet Bay, B. C. : – Able to kill bacteria that have become resistant to antibiotics – Heilsuk First Nation has been using the clay for hundres of years to treat ulcers, arthritis, burns, and skin disorders – http: //kisameetclay. com UBC researchers have found that Kisameet clay can kill pathogens that are resistant to modern medicines

Concept 1: Traditional First Peoples medicines and treatments come from resources in nature. Medicinal plants used by First Peoples of B. C. : • Indian hellebore – Found in open forests – Used by Nuxalk Nation to treat skin and scalp conditions – Smoke from a burned plant can be used as a decongestant Figure 1. 23: Indian hellbore (Veratrum viride)

Concept 1: Traditional First Peoples medicines and treatments come from resources in nature. • Devil’s club – Grows along the coast and in the B. C. interior – Treats breathing and digestive disorders, arthritis, and diabetes Figure 1. 23: Devil’s club (Opolopanax horridus)

Concept 1: Traditional First Peoples medicines and treatments come from resources in nature. • Pacific yew tree – Grows along the coast – Tea from the needles and bark treats pain and internal injuries – Bark contains a cancerfighting chemical that is the basis of the drug Taxol (used to treat breast and ovarian cancers) Figure 1. 23: Pacific yew (Taxus brevifolia)

Discussion Questions • How can nature be used to heal? • Why might it be important to identify and preserve plants used for medicinal purposes?

What is the Immune System? • The body’s defense against disease causing organisms, malfunctioning cells, and foreign particles

History: Preventing Disease 1. Vaccinations 2. Hygeine

Smallpox • Smallpox was an endemic (regional outbreak) viral disease that first appeared in 10, 000 BC and was officially eradicated December 1979 through world wide vacciations • Approximately 30% fatality rate • Permenant scars from disease • No cure for smallpox, only prevention

Mary Montagu’s Observations • English writer • In 1717, she observed Turkish women “protecting” their children from the deadly smallpox

1717 Smallpox Prevention 1. Obtain pus from a victim with a mild case of smallpox 2. Cut “healthy” child’s arm and add pus 3. Child becomes covered with pus-filled blisters • Mild case of smallpox • Heals quickly • Severe case will not develop in the future

Mary Montagu • Montagu tested this procedure with English prisoners • She helped to remove smallpox from England

Edward Jenner’s Scientific Experiments • 1796, this English Doctor noticed people infected with cowpox did not contract smallpox in the future • Jenner’s Hypothesis: IF a person is exposed to cow pox THEN they will not contract smallpox

Edward Jenner • Tested his hypothesis using an eight-year-old boy.

Smallpox has been eradicated thanks to vaccinations

Vaccines • Both Montagu and Jenner were performing vaccinations well before the pathogens and the immune system were understood • Modern vaccines: – Weakened form of pathogen – Stimulates the production of antibodies – If pathogen enters body in future antibodies are ready to recognize it

Vaccines and Public Health • Benefits of vaccination: – Help protect people against deadly diseases and those that cause permanent damage – Help stop the spread of disease – Help stop an outbreak from turning into an epidemic or pandemic • Example: Smallpox was eradicated in 1980

Get ready for Grade 9!

Vaccination • Booster shots are vaccines that stimulate antibody production again • All grade 9’s in BC get a booster shot for: – Tetanus – Diptheria – Pertussis

Immunization Schedule for B. C. Babies

Immunization Schedule for B. C. Babies (continued)

Immunization Schedule for B. C. School Age Children

Table 1. 6: Effectiveness of Certain Vaccines

Concept 3: Antibiotics can treat bacterial infections. • Antibiotics: – A substance that fights infections by interfering with the life processes of bacteria – Kill bacteria or prevent them from growing or reproducing – Not effective against viruses or other microbes
Penicillin – The First Antibiotic Available on a Global Scale • Discovery of penicillin: – 1928: Alexander Fleming grew Staphyloccocus bacteria on a Petri dish – The dish had a large patch of mould, but no bacteria growing around the mould – Penicillin was derived from this mould – Penicillin-based antibiotics: erythromycin, tetracycline Figure 1. 24: The area near the mould does not have bacteria growing around it.

The Development of Antibiotic-Resistant Bacteria • Overuse of antibiotics has led to antibiotic-resistant bacteria. – Some diseases (pneumonia, tuberculosis) are now more difficult to treat – “Superbugs”: bacteria that are resistant to several types of antibiotics • Example: methicillinresistant S. aureus (MRSA) Methicillin-resistant Staphylococcus aureus (MRSA)

Figure 1. 25: How a population of bacteria develop resistance to antibiotics (A) • An antibiotic is added to a colony of bacteria. • A few bacteria have mutations that enable them to resist the antibiotic.

Figure 1. 25: How a population of bacteria develop resistance to antibiotics (B) • The antibiotic kills the nonresistant bacteria. • The resistant bacteria survive and reproduce.

Figure 1. 25: How a population of bacteria develop resistance to antibiotics (C) • Surviving bacteria are added to another plate containing more of the same antibiotic.

Figure 1. 25: How a population of bacteria develop resistance to antibiotics (D) • The antibiotic now affects only a small percentage of the bacteria. • The surviving bacteria continue to reproduce. • Most of the bacteria are resistant to the antibiotic.

Discussion Questions • What are antibiotics? How are they used? • How would you describe antibiotic-resistant bacteria to a grade 3 class?

Discussion Questions • Why do you think the medical community is concerned about antibiotic -resistant bacteria?

Summary: What medicines help protect us from microbes that make us sick? • Traditional First Peoples medicines and treatments come from resources in nature. • Vaccines can help us prevent infections. • Antibiotics can treat bacteria infections.
- Slides: 34